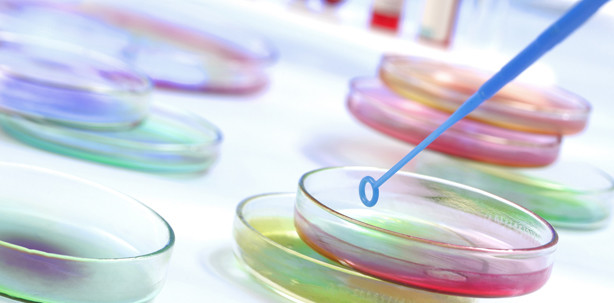
Doppelschlag gegen Killerkeime

Branchenmeldungen 12.02.2014
Doppelschlag gegen Killerkeime
Eine Art Schlafzustand scheint manche Bakterien – so genannte Methicillin-resistente Staphylokokken (MRSA) – vor Antibiotika zu schützen. Diese Entdeckung nutzten Biologen aus Boston (USA) für eine neue Strategie gegen die Problemkeime: Sie „weckten“ sie mit Hilfe eines bestimmten Eiweißstoffes (ADEP) und aktivierten dabei ein Enzym.
Im Tierversuch war die Kombination aus ADEP und herkömmlichen Antibiotika gegen MRSA zuverlässig erfolgreich, berichtet die „Apotheken Umschau“. Zwar könnten die Bakterien auch gegen dieses Medikament resistent werden, doch würden sie insgesamt wieder angreifbar, so die Wissenschaftler.
Quelle: ots/Apotheken Umschau 1/2014 A